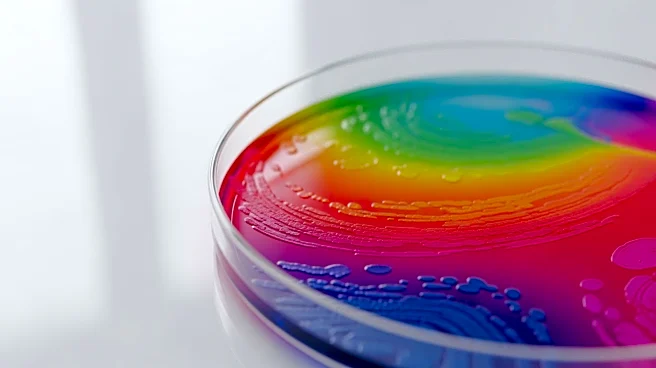
Researchers Explore Gut Microbiome's Role in Longevity and Health

What's Happening?
Japan's national baseball team is preparing to defend its title in the upcoming World Baseball Classic (WBC). Historically dominant, Japan has won three of the five WBC tournaments held so far. The team is known for its strong lineup and pitching staff,
which includes MLB stars like Shohei Ohtani and Yoshinobu Yamamoto. Ohtani, who was pivotal in Japan's 2023 victory, will focus solely on hitting this time, while Yamamoto will lead the pitching rotation. The team also features other MLB players such as Seiya Suzuki and Masataka Yoshida, alongside top talents from Japan's Nippon Professional Baseball (NPB) league. Manager Hirokazu Ibata has a wealth of talent to choose from, with a lineup that includes power hitters and skilled pitchers, making Japan a formidable contender in the tournament.
Why It's Important?
Japan's performance in the World Baseball Classic is significant as it highlights the country's continued dominance in international baseball. The team's success not only boosts national pride but also enhances the global reputation of Japanese baseball. For MLB, the participation of players like Ohtani and Suzuki in the WBC increases the tournament's visibility and appeal, potentially attracting more international fans to the league. Additionally, the WBC serves as a platform for NPB players to showcase their skills on a global stage, which could lead to more Japanese players transitioning to MLB, further enriching the league's talent pool.
What's Next?
As the World Baseball Classic approaches, Japan will finalize its roster and strategies to maximize its chances of retaining the title. The team will likely focus on maintaining its strong offensive and defensive capabilities while adapting to the challenges posed by other strong teams like the USA and the Dominican Republic. The tournament will also be an opportunity for emerging Japanese players to gain international experience and for MLB scouts to identify potential new talent. The outcome of the WBC could influence future collaborations and exchanges between MLB and NPB, fostering a deeper connection between the two baseball cultures.